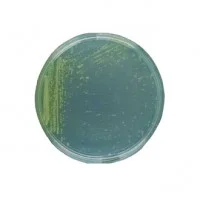
محیط کشت کینگ بی
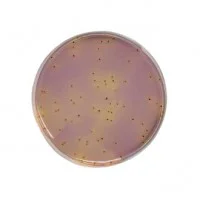
استرپتوکاس آگار KF Streptococcus Agar
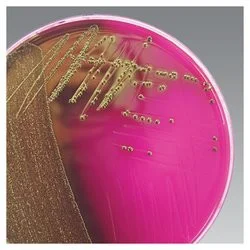
محیط کشت ام-اندو آگار

محیط کشت
محیط کشت (Culture Medium) به مجموعهای از مواد مغذی، معدنی و فاکتورهای رشد گفته میشود که بهصورت جامد، نیمهجامد یا مایع تهیه شده و برای رشد، تکثیر و نگهداری میکروارگانیسمها یا سلولها مورد استفاده قرار میگیرد. این محیطها بهگونهای طراحی میشوند که نیازهای متابولیکی موجود زنده هدف را برآورده کنند.
نکته کلیدی:
هر نوع موجود زنده، به محیط کشتی با ترکیب و شرایط خاص نیاز دارد و انتخاب محیط نامناسب میتواند منجر به عدم رشد یا نتایج نادرست آزمایشگاهی شود.
اهمیت محیط کشت در علوم آزمایشگاهی
اهمیت محیط کشت تنها به رشد میکروارگانیسمها محدود نمیشود، بلکه نقش حیاتی در تشخیص، تحقیق و تولید صنعتی دارد:
-
تشخیص بیماریهای عفونی
-
شناسایی باکتریها، قارچها و ویروسها
-
تحقیقات ژنتیک و مولکولی
-
تولید واکسن، آنتیبیوتیک و آنزیم
-
کشت سلولهای جانوری و گیاهی
-
کنترل کیفیت در صنایع غذایی و دارویی
بدون محیط کشت استاندارد، بسیاری از فرآیندهای تشخیصی و تحقیقاتی عملاً غیرممکن هستند.
اجزای اصلی محیط کشت
۱. منبع کربن
کربن یکی از عناصر اساسی برای ساختار سلولی است. منابع متداول کربن شامل:
-
گلوکز
-
لاکتوز
-
سوکروز
-
مانیتول
انتخاب منبع کربن میتواند به شناسایی میکروارگانیسمها کمک کند.
۲. منبع نیتروژن
نیتروژن برای ساخت پروتئینها و اسیدهای نوکلئیک ضروری است:
-
پپتون
-
عصاره مخمر
-
آمونیوم سولفات
-
نیتراتها
۳. املاح معدنی
املاحی مانند:
-
سدیم
-
پتاسیم
-
منیزیم
-
آهن
-
فسفر
برای حفظ تعادل اسمزی و فعالیت آنزیمی ضروری هستند.
۴. فاکتورهای رشد
برخی میکروارگانیسمها به ترکیبات خاصی نیاز دارند:
-
ویتامینها
-
اسیدهای آمینه
-
نوکلئوتیدها
-
سرمها (در کشت سلولی)
۵. عامل جامدکننده
برای محیطهای جامد:
-
آگار (رایجترین)
-
ژلاتین (کمکاربردتر)
آگار در دمای بدن ذوب نمیشود و برای کشت میکروبی ایدهآل است.
انواع محیط کشت
انواع محیط کشت از نظر فیزیکی
محیط کشت مایع
-
فاقد عامل جامدکننده
-
مناسب برای تکثیر سریع
-
مثال: Nutrient Broth
محیط کشت نیمهجامد
-
دارای مقدار کم آگار
-
مناسب بررسی تحرک باکتری
-
مثال: Motility Test Medium
محیط کشت جامد
-
دارای آگار
-
مناسب مشاهده کلنیها
-
مثال: Nutrient Agar، Blood Agar
انواع محیط کشت از نظر کاربرد
۱. محیط کشت عمومی (Simple Media)
-
برای رشد باکتریهای غیرسختگیر
-
مثال: Nutrient Agar
۲. محیط کشت غنیشده (Enriched Media)
-
دارای خون، سرم یا فاکتورهای اضافی
-
مثال: Blood Agar، Chocolate Agar
۳. محیط کشت انتخابی (Selective Media)
-
جلوگیری از رشد فلور ناخواسته
-
مثال: MacConkey Agar
۴. محیط کشت افتراقی (Differential Media)
-
تمایز میکروارگانیسمها بر اساس واکنش بیوشیمیایی
-
مثال: EMB Agar
۵. محیط کشت انتقالی (Transport Media)
-
حفظ نمونه تا رسیدن به آزمایشگاه
-
مثال: Stuart Medium
۶. محیط کشت نگهدارنده
-
حفظ سویهها برای مدت طولانی
-
مثال: Glycerol Stocks
محیط کشت مایع
محیط کشت مایع (Liquid Culture Medium) ترکیبی محلول از مواد مغذی، منابع کربن و نیتروژن، نمکهای معدنی، ویتامینها و گاهی فاکتورهای رشد اختصاصی است که برای پرورش میکروارگانیسمها در حالت معلق مورد استفاده قرار میگیرد.
در این محیط، سلولها بهصورت آزاد در فاز مایع رشد میکنند و تماس مستقیم با مواد غذایی دارند، که این موضوع باعث افزایش راندمان جذب مواد و تسریع رشد میشود.
تفاوت محیط کشت مایع با محیط کشت جامد
تفاوت اصلی محیط کشت مایع با محیط کشت جامد در عدم وجود ماده جامدکننده مانند آگار است. در محیط مایع:
-
رشد میکروارگانیسمها بهصورت کدورت (Turbidity) مشاهده میشود
-
امکان همزدن، هوادهی و کنترل دقیق شرایط رشد وجود دارد
-
بررسی سرعت رشد، تولید متابولیت و تغییرات فیزیولوژیک سادهتر است
در حالی که محیط جامد بیشتر برای تشخیص مورفولوژی کلنی و جداسازی سویهها کاربرد دارد.
محیط کشت جامد
محیط کشت جامد (Solid Culture Media) نوعی محیط کشت میکروبی است که با افزودن عامل جامدکننده—معمولاً آگار (Agar)—به محیط پایه تهیه میشود. این عامل باعث میشود محیط پس از سرد شدن به حالت ژلهای پایدار درآید و سطحی مناسب برای رشد سطحی میکروارگانیسمها ایجاد شود.
نکته کلیدی:
آگار مادهای پلیساکاریدی است که توسط اغلب میکروارگانیسمها تجزیه نمیشود و در دمای انکوباسیون پایدار باقی میماند.
اجزای اصلی محیط کشت جامد
محیطهای کشت جامد، بسته به نوع کاربرد، میتوانند ترکیبات متفاوتی داشته باشند، اما بهطور کلی شامل اجزای زیر هستند:
۱. منبع کربن
-
گلوکز، لاکتوز یا سایر قندها
-
تأمین انرژی برای رشد میکروارگانیسمها
۲. منبع نیتروژن
-
پپتون، عصاره گوشت یا مخمر
-
ضروری برای سنتز پروتئینها و آنزیمها
۳. نمکها و مواد معدنی
-
سدیم کلرید، فسفاتها
-
حفظ تعادل اسمزی و تنظیم pH
۴. عامل جامدکننده
-
آگار (۱٫۵ تا ۲ درصد)
-
ایجاد ساختار جامد و سطح رشد
۵. ترکیبات انتخابی یا افتراقی (در صورت نیاز)
-
آنتیبیوتیکها، رنگها یا معرفها
-
تفکیک یا مهار رشد برخی میکروارگانیسمها
محیط کشت نیمه جامد
محیط کشت نیمهجامد نوعی محیط کشت میکروبی است که مقدار کمی ماده جامدکننده، معمولاً آگار (حدود ۰٫۲ تا ۰٫۵ درصد) در ترکیب خود دارد. این مقدار آگار باعث میشود محیط نه کاملاً مایع و نه کاملاً جامد باشد، بلکه حالتی ژلهای و نرم داشته باشد. این ویژگی فیزیکی امکان حرکت محدود باکتریها در محیط را فراهم کرده و شرایطی ایدهآل برای آزمایشهایی مانند بررسی تحرک (Motility) ایجاد میکند.
ترکیبات اصلی محیط کشت نیمهجامد
محیطهای کشت نیمهجامد بسته به نوع کاربرد میتوانند ترکیبات متفاوتی داشته باشند، اما بهطور کلی شامل اجزای زیر هستند:
-
منبع کربن و انرژی مانند گلوکز یا سایر قندها
-
منبع نیتروژن شامل پپتون یا عصاره گوشت
-
نمکهای معدنی برای حفظ تعادل اسمزی
-
آگار با غلظت کم بهعنوان عامل نیمهجامدکننده
-
در برخی موارد شناساگرهای pH یا ترکیبات انتخابی
نکته مهم:
غلظت پایین آگار، عامل اصلی ایجاد ساختار نیمهجامد و عملکرد ویژه این محیطها است.
خرید محیط کشت باکتری
برخی از محیط های کشت در آزمایشگاه بسیار استفاده می شوند و جزء پرکاربرد ترین محیط های کشت به حساب میآید. ما در این مقاله پرکاربردترین محیط های کشت را نیز برای شما شرح می دهیم. از پرکاربردترین محیطهای کشت عبارتند از:
محیط کشت نوترینت آگار: محیط کشت معمولا برای ساخت شکلات آگار و یا خون آگار بسیار مناسب می باشد.

خرید محیط کشت
محیط کشت نوترینت براث: معمولاً بیشتر محیط های کشت از این محیط ساخته می شوند و دارای عصاره گوشت می باشند. از آنجایی که نمی توان آگار را به صورت مایعی داشت به همین دلیل در لوله آزمایشگاهی آن را تهیه می کنند.
خرید محیط کشت میکروبی
محیط کشت آگار خون دار: معمولا در رشته های میکروب شناسی از این محیط کشت استفاده می کنند. محیط کشت مکان بسیار مناسبی برای رشد بیشتر باکتری ها می باشد. مخصوصا باکتری هایی که خیلی سخت رشد هستند. معمولاً آگار خوندار می تواند تا یک هفته در یخچال بماند.
شرکت های فروشنده محیط کشت میکروبی
محیط کشت شکلات آگار: باکتری های هوازی که بسیار سخت رشد هستند، این محیط کشت برای ان ها بسیار مناسب است. این محیط کشت مواد غذایی و هموگلوبین زیادی دارد که می تواند زمینه را برای کشت باکتری و سلول به وجود بیاورد و معمولاً پایه ی این محیط کشت را حرارت می دهند و مقداری خون به آن اضافه میکند.
محیط کشت ها از نظر مواد تشکیل دهنده دارای انواع مختلفی هستند.
انواع مختلف محیط کشت از نظر مواد تشکیل دهنده کدام است؟
شرکت های تولید کننده محیط کشت میکروبی
محیط کشت عمومی و یا پایه: این محیط مواد غذایی بسیار کمی برای رشد باکتری ها وجود دارد و به نوعی می توان گفت که این محیط کشت پایه برای به وجود آمدن دیگر محیط های کشت می باشد. معمولا از آنجایی که این محیط کشت فاقد مواد ضد میکروبی است، سلول و میکروب های بسیار زیادی در این محیط کشت رشد میکند.
محیط کشت غنی شده
محیط کشت غنی شده: محیط کشت بر خلاف محیط کشت قبلی دارای مواد مغذی است که برای رشد باکتریها بسیار مناسب و لازم است. باکتری های بسیار زیادی در این محیط رشد می کند.
محیط کشت انتخابی: معمولا این محیط های کشت را به تشخیصی انتخاب می کنند. انواع مختلفی از باکتری ها و سلول ها در این محیط کشت رشد می کند.
محیط کشت کامل
محیط کشت کامل: به طور کلی این محیط کشت دارای مواد مغذی بسیار زیادی است و از آنجایی که مواد ضد میکروبی نیز ندارد بسیاری از باکتری ها اگر در این محیط رشد کنند هیچ نشانهای از خودشان به جا نمی گذارند.
محیط کشت افتراقی
محیط کشت افتراقی: معمولاً اگر بخواهند نوع خاصی از سلول ها را جدا کنند این محیط کشت را انتخاب می کنند. معمولاً برای جدا کردن سلول ها و یا باکتری ها قابل استفاده است.

فروش محیط کشت
دارای مایع ژلی می باشد که به عنوان رشد دهنده ی میکروب ها، یاخته ها و حتی گیاهان کوچک مورد استفاده قرار میگیرد و به طور عمده 2دسته است
محیط کشت یاخته ای و محیط کشت خرد زیستی
(کشت یاخته ای ) و کشت خرد زیستی
که هر دو با هدف خاص و نحوه رشد برخی ترکیبات عمل می کنند.
خرید محیط کشت آزمایشگاهی
کشت یاخته در جهت بهبود فرایند رشد گیاهان و حیوانات که منشاء یاخته ای دارند کاربردی است اما برخلاف آن کشت خرد زیستی تنها به فرایند رشد میکروب کمک می کند البته ما محیط های کشتی متنوعی از قبیل کشت مغذی 2- کشت انتخابی 3-تمایزی 4-غنی شده که هر کدام مخصوص یک ترکیب و یک هدف ویژه هستند رشد باکتری های توسعه یافته در کشت مغذی موثر است زیرا دارای آب مواد کربنی چون گلوکز و نمک و آمینو اسید است که تقویت و رشد میکروب ها را بسیار افزایش می دهد اما کشت دیگری تنها میزان دریافت خوراکی و عناصر حیاتی را کنترل و مانع از دریافت هرگونه آمینو اسید است در اصل کار اصلی محیط کشت اندازه گیری میزان دریافت اکسیژنی که گیاه نیاز دارد است و نیاز به ریزاندامگان هم دارد چون ریزاندامگان هستند که به محیط کشت نیاز دارند و همچنین بی هوازی و هوازی هستند و البته محیط مصنوعی برای رشد کشت و تاکثیر هرگونه باکتری قابل اعمال است البته برای کشت باید شرایطی هم موجود باشد و محیط کشت با توجه مقدار نیاز به صورت مایع و جامد قابل آماده سازی است محیط مایع و محیط کشت جامد و ژله ایی کلا در بیان ساده محیطی که قادر به رشد و تاکثیر سلول ها است و بیشتر برای کارهای تحقیقاتی و آزمایشگاهی قابل انجام است و در محیط کشت برخی وسایل از قبیل فاکتور رشد که ماده ایی است که قابلیت تحریک سلول ها را برای رشد دارا است و تنظیم و چک محیط اطراف از نظر PHو فشار اسمزی و محیط کشت باید دارای اجزای غذایی ضروری باشد و تنها نکته مهم در محیط کشت غلظت محلول نمکی است باید فشار اسمز و یون های فلزی را به حد تعادل برساند تا کارکرد پروتئین ها مناسب باشد و از رنگ فنول رد درجهت نشان دهنده PH استفاده می شود چون مقدار PH در محیط کشت مهم است تا مقدار رنگ و اسیدی بودن را نمایش دهد محیط کشت دارای ویژگی چون جدا سازی شناخت اجزا سازی تشخیص و تسهیل سلول ها است و برخی از محیط های کشت نسبت به سایر محیط ها ساده تر هستند و دارای فاکتور رشد برای رشد سلول ها است و برخی منبع جلوگیری از رشد باکتری های آلوده کننده هستند که بر پایه آگار پایدار هستند و قادر به تشخیص باکتری ها با رنگ کلونشان وجود دارد و از نظر شکل کلونی قابل تمیز شدن هستند و نباید زغال مورد استفاده قرار گیرد زیرا باعث می شود عوامل منع کننده خنثی شود و علاوه بر این که محیط کشت بستگی به میزان pH دارد باید درجه حرارت را هم مد نظر داشته باشیم تا مبادا موادمغذی موجود در حال تزریق به گیاه از بین رود وظروف منتخب برای کشت باید پاکسازی و عاری از هرگونه آلودگی باشد که مبادا به روند رشد صدمه ای واردکند و اگر محیطی فاقد آگار باشد به صورت مایع در لوله آزمایشی به اسم ارلن شرایط موجود را ایفا می کنند و برخی دارای آگار مناسب با توجه به شرایط موجود هستند و برخی محیط های کشت بر اساس نوع مواد تشکیل میشوند مثل محیط کشتی که دارای ماده ای مهار کننده برای جلوگیری از رشد ارگانیسم هایی که بیش از حد تشکیل می شوند لازم است و برخی دارای مواد مغذی با توجه به شرایط بهینه دارا هستند تا شرایط رشد گیاه را کامل تکمیل کنند خود محیط کشت مایع و جامد دو بخش و بخش های گوناگون دارند بخش مهمش فقط بخش لوله و پلیت است البته خود روش پلیت در محیط کشت جامد سه بخش دارد
که شامل کشت خطی کشت محیط و کشت های دولایه
محیط کشت خطی
کشت خطی دور نوک حلقه ای جامد شرایط رشد فراهم می شد. در کشت محیط مقداری روی سطح جامد ریخته و با میله پخش می کنیم
کشت دولایه مواد ذوب شده را ب جامد ریخته پس از شکل گیری پلیت را به صورت واژگون در گرماخانه قرار می دهیم البته در روش کشت مایع پلیت سه بخش تقسیم بندی شده خطی ،سطحی و آمیخته که هریک خصوصیات و ویژگی هایی دارند

در نظر داشته باشید که محیط کشت ترابری هدفی بر مبنای نگهداری جانداران و جابه جابه ذخیره ی آن به کار می رود و تنها برای یک نمونه جاندار قابل استفاده است زیرا در جهت رشد طیف گسترده ایی از جانداران مشغول است و برخی که باید به صورت بالینی بررسی شود البته شرایط ویژه برای محیط کشت
شامل دما ی ویژه و حرارت انتقال دهنده و کنترل مقدار PH مصرفی است که اگر کنترل شود محیط کشت به صرفه ایی تولید می شود و باید دارای محیط مغذی کافی هم باشد که به صورت ژل مایع و اسیدی برای رشد تزریق شود و ویتامینه هایی دارند که این شرایط و مواد مغذی برای رشد تک یاخته و باکتری و جلبک ها موثر است و این مایع ژله ایی ممکن قهوه ایی رنگ و تولید شده از آگار باشد و ممکن است که برخی فاقد آگار باشند و نام محیط کشت مایع به خود بگیرند
و تنها مواد مغذی در طی روند تولید به کار نرود ممکن است مواد شیمیایی هم به کار رود
و چون دارای ترکیبات خاصی است که باعث رشد میکرو ارگانیسم ها می شود و دارای املاح و کریستال ویوله برای رشد مناسب باکتری ها است
البته مانع از رشد باکتری های گرم و مثبت می شود و محیط کشت TSI محیطی جامد و افتراقی است که در جهت تشخیص باکتری روده ها قابل استفاده است و برای رشد باکتری های مشکل پسند قابل حل است و می توان کمکی برای رشد باکتری های گرم و منفی روده باشد
و همچنین محیط کشتی که دارای ترکیب شیمیایی است محیط کشت پایه که داخل خود حدقل مواد مغذی به کار رفته است
موادی چون آگار و ……
محیط کشت غنی
که در سرم و خون قابل دریافت است موجود در ویتامین ها. برخی محیط ها تنها قابل رشد گروهی از باکتری های خاص هستند و در نظر داشته باشید که میکروب مورد نیاز برای رشد تک سلولی است و قادر به تولید و رشد مستقلانه است به طوری که محیط کشت می تواند دست ساز و طبیعی هم تولید شود و داخل سلول رشد شایانی داشته باشد خون به رشد بهتر باکتری کمک رسانی می کند می تواند در ظروف و سطح های گوناگون کشت داده شود برای باکتری ها سه نوع محیط کشت قرار داده شده است
که مهم ترینشان محیط کشت آبگوشتی است چون دو درصد آگار جزو مواد مغذی به همراه دارد مثل محیط کشت
TSI
M.C
محیط کشت آگار خوندار و محیط کشت آگار شکلاتی جزوی از محیط های کشت میکروبی به شمار می آیند
محیط کشت عمومی چیست؟
محیطی که شرایط لازم دارای مواد مغذی کاملی را برای رشد و فراهم کرد میکروارگانیسم ها ایجاد میکند و PH این محیط بسیار حساس هستند و در زمان مشخص و ثابتی باقی می مانند و برخی دارای محیط بی هوازی هستند که مخصوص رشد باکتری هایی هستند که نیاز به هوایی ندارند و حاوی آب و مواد مغذی هستند
TSA محیط مناسب رشد باکتری هایی است که به اکسیژن دارند
به غیر از این مورد محیط کشت باید دارای 20گرم در لیتر آگار دریافت کند زیرا آگار به عنوان منبع غذایی بالا به شمار می رود اگر موجود نباشد به عنوان محیط کشت براث دیده می شود و افزایش باکتری به طور کامل انجام نمی شود و نوع محیط کامل بستگی به شرایط تامین کننده مواد مغذی دارد ممکن است هم انتخابی و افتراقی باشد چون برخی محیط که آگار متناسبی دارند می توانند باکتری گرم و منفی را دریافت کنند و به عنوان تست بیهوشی و تشخیص بسیار به کار برده می شود و همینطور است که محیط کشت ممکن است دارای دو نوع تقسیم بندی باشد که هر نوع با توجه به نیاز باکتری شرایط ویژه را طراحی و عملکرد باکتری را در نظر می گیرد چون با هدف تکثیر در محیط گوناگون پا پیش می گذارد و برخی محیط ها دارای اشکالاتی هستند که در ابتدا اشاره خواهد شد
لوله ی محیط کشت دارای یک غشای نازک است که ترکیبات محیط کشت را به صورت شناور ارائه می دهد
و لوله اصلا شفاف نیست و مه آلود است و سریع موجب رسوب گذاری و ته نشینی ترکیبات می شود محیط کشت آگار خوندار بهترین محیطیست که سرشار از مواد مغذی است و باعث شده که همولیز بر روی این ترکیبات به راحتی انجام شود و همچنین پس از تهیه محیط باید آگار به پایه برسد تا خنک شود و مقداری خون دریافت کند و در برخی محیط ها گلبول قرمز لیز موجود است که توسط این گلبول ها رشد مغذی باکتری ها تامین می شود و به عنوان محیط پایه قابل شناخت است و محیط (MAC)
حاوی موادی چون پروتئین ، کلرید سدیم، کریستال ویوله و سایر موارد می باشد و عمل انتخابی محیط بستگی به کریستال ویوله و نمک صفراوی دارد که نشان دهنده این است که رشد گرمی دارند اما گاهی دیده شده که محیط کشت قرمز رنگ است به دلیل لاکتوز و تخمیر موجود در آن است البته خود لاکتوز ها به تنهایی کلون بی رنگ تولید می کنند محیط SS محیطی است که به عنوان جلوگیری کننده عمل می کند و مانع از رشد هرگونه باکتری های گرم و منفی می شود در واقع حکم محیط انتخاب کننده را ایفا می کند و از مدفوع نمونه برداری بالایی انجام می دهند و گاهی تغییر رنگ محیط از سبز به آبی رخ می دهد که نشان دهنده تست مثبت و توانایی های باکتری به عنوان استفاده از مالونات سدیم است و محیط دیگر به عنوان بررسی توانایی حرکت باکتری و احیای گوگرد انتخاب شده است و در تست اندول قابل استفاده است و اگر محیط کشت تغییر رنگ ندهد نشان دهنده ی کمبود تخمیر قند است کشت چهار مرحله ایی روش پر کاربردیست که برای به دست آوردن تک کلنی و یافت تغییرات ناشی است کشت چمنی هم کشت یکنواخت و سطحی است برای پخش یکنواخت و رشد باکتری ها قابل استفاده است البته این یکنواختی که توسط سوآپ انجام شود بهینه و در زمان کمتر قابل استفاده است البته اگر کشت ماده ی اولیه باکتری ما به صورت مایع باشد و البته می توان باکتری را هم روی سطح جامد پخش کرد البته به شرطی که کمک کننده ایی هم وجود داشته باشد البته کشت چند بخشی هم موجود است بهرای صرفه جویی در مصرف کشت به مدت کوتاه انجام می شود البته ما دارای کشت عمقی هستیم که توسط لپ سوزنی انجام می شود که در جهت حرکت باکتری به کار می رود در نظر داشته باشید محیط کشت نیمه جامد در لوله های آزمایش انجام می شود که در سمت چپ باکتری در مسیر رشد کشت می شود چون در مسیر چپ توانایی حرکت ندارد اما در مسیر سمت راست کدر است و شفافیت سمت چپ را ندارد اما توانایی حرکت در کل مسیر پخش می شود و در شرایط کم هوا از محیط کشت شیب دار استفاده می کنند که در ته لوله آزمایش قابل دید است البته محیط های کشت جامد حالتی که دارند به عنوان معرفی ترکیب شیمیایی و انجام تخمیر و تولید اسید توسط باکتری انجام می شود که شرایط کم هوا را تحمل می کند و باکتری های بی هوازی برای رشد باید در ظرف بسته ای به نام جار قرار گیرد البته در جار یک شمع قرار می دهند که هوای موجود را در بر گیردتا تمام اکسیژن را مورد استفاده قرار دهد تا شرایط بی هوازی یکسانی تمام محیط را برای میکروب های بی هوازی دربرمیگیرد
و نمونه هایی از کشت
خون و عفونت ادراری و تزریق خون است که کشت خونی را تولید می کند
کشت خون برای بیماران با علائم بیماری یا حاد مشکلات بالاتر قابل استفاده است در انجام این کشت عفونت نقش ارزنده ایی دارد به طور کلی کشت های متنوعی موجود است که با توجه به شرایط دارنده انتخاب و مورد استفاده قرار می گیرند
خرید محیط کشت
محیط کشت در انواع گوناگونی در فروشگاه آنلاین و دارای نماد اعتماد الکترونیکی آریا طب با قیمت مناسب به فروش می رسد می توانید از طریق همین سایت نسبت به خرید آنلاین این محصولات اقدام نمایید.
فروش محیط کشت
تیم متخصص فروشگاه تجهیزات و دستگاه های آزمایشگاهی آریا طب همواره می کوشد تا با ارائه خدمات مناسب و مورد نیاز مشتریان همچون مشاوره خرید تجهیزات و مواد ازمایشگاهی، تجهیزات مطب ها و کلینیک ها و دستگاه های آزمایشگاهی نیاز آن ها را به تجهیزات پزشکی مرتفع سازد پس چنانچه قصد خرید دستگاه اتوکلاو را دارید همین حالا با مشاوران ما تماس حاصل نمایید و تمامی سوالات و ابهامات خود را برطرف نمایید و سپس نسبت به خرید مناسب ترین ست اقدام نمایید. امروزه خرید آنلاین به دلیل های مختلفی همچون سرعت بالا، حذف هزینه رفت و آمد، عدم اتلاف وقت و ... دارای طرفداران بسیاری بوده و رواج گسترده ای پیدا کرده می باشد به همین دلیل مدیران آریا طب شرایطی را مهیا کرده اند تا خرید از این فروشگاه به صورت آنلاین نیز امکان پذیر باشد پس برای خرید به صورت اینترنتی به صفحه معرفی محصولات رفته و با انتخاب محصول مورد نظر و اضاف کردن آن به سبد خرید خود، فرم مربوطه را تکمیل نمایید سپس از طریق درگاه بانکی مربوطه هزینه آن را پرداخت کرده تا سفارش شما به مرحله ثبت نهایی برسد و همکاران ما در اسرع وقت آن را درب منزل یا محل کارتان به شما تحویل دهند.

